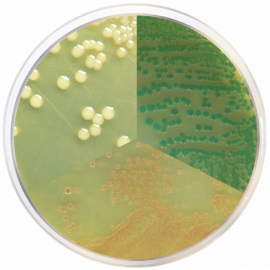

Condalab은 미생물학 및 분자생물학용 분말 배지(Dehydrated culture media)의 스페인 최초이자 세계적으로 선도적인 제조업체입니다.
제품 설명
Vibrio Chromogenic Agar
제품 번호
2054
제품 설명
| Glucose | 1 | Bacteriological agar | 15 | |
| Chromogenic mixture | 2.49 | Lactose | 0.1 | |
| Peptone | 10 | Sodium chloride | 10 | |
| Sodium cholate | 3 | Sodium citrate | 10 | |
| Sodium thiosulfate | 10 | Sucrose | 20 | |
| Yeast extract | 3 | Special bilis | 5 |
Condalab의 모든 제품을 만나보세요!
Culture media for clinical diagnosis
CondaChrome® Chromogenic culture media
Antimicrobial susceptibility testing
Pharmaceutical and Animal Health
Antimicrobial susceptibility testing
Condagene®: PCR Real Time kits for pathogen detection
Condalab - Official Distributor in South Korea "Morebio" 한국 공식 대리점 "모아바이오"